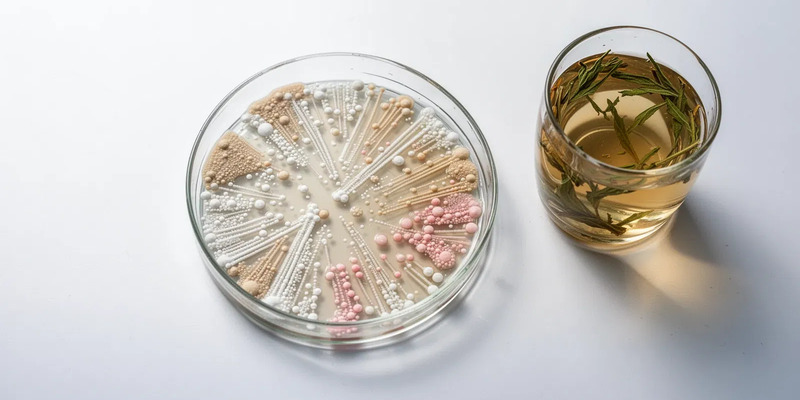
Buchinger-Fasten: Neustart für den Darm durch Mikrobiom-Regeneration - Foto: über boerse-global.de

Buchinger-Fasten: Neustart für den Darm durch Mikrobiom-Regeneration
08.02.2026 - 04:23:12Das Heilfasten nach Buchinger kann das Darm-Mikrobiom tiefgreifend regenerieren. Neue Forschungserkenntnisse zeigen: Der gezielte Nahrungsverzicht wirkt wie ein Reset für die Billionen Bakterien in unserem Darm und legt so den Grundstein für bessere Gesundheit.
Wie Fasten die Darmflora umbaut
Während einer Fastenkur nach Buchinger stellt der Körper seinen Stoffwechsel radikal um – der sogenannte „metabolic switch“. Sobald die Zuckervorräte aufgebraucht sind, zapft er die Fettreserven an. Diese Umstellung verändert auch die Lebensbedingungen im Darm dramatisch.
Studien, unter anderem mit den Buchinger Wilhelmi Kliniken, belegen eine signifikante Verschiebung der Bakterienpopulation. Kohlenhydrat-verarbeitende Stämme wie Lachnospiraceae gehen zurück. Gleichzeitig vermehren sich Bakterien, die von Schleim und abgestorbenen Darmzellen leben, etwa Bacteroidetes.
Diese nieuwe Balance entlastet das Verdauungssystem. Die Darmschleimhaut erhält eine Pause und kann sich regenerieren – ein Effekt mit potenziell therapeutischer Wirkung bei geschädigtem Darm.
Passend zum Thema Mikrobiom und Blutwerte – viele Laborwerte sind ohne Kontext schwer zu deuten. Der 25-seitige PDF-Report erklärt verständlich TSH, Cholesterin, Leukozyten und weitere Vitalwerte, zeigt, welche Werte wirklich zählen und welche Spezialtests Sinn machen. So wissen Sie, ob gemessene Veränderungen nach dem Fasten normal sind oder ärztliches Handeln nötig ist. Kostenlos per E‑Mail. Kostenlosen Laborwerte-Report anfordern
Der Schlüssel liegt in der Aufbauphase
Die Fastenzeit selbst ist nur die Hälfte der Reise. Entscheidend für den langfristigen Erfolg ist die sorgfältige Aufbauphase danach. Hier wird das Mikrobiom neu strukturiert.
- Während des Fastens kann die Bakterienvielfalt kurzzeitig sinken.
- Das schrittweise „Fastenbrechen“ mit leichter, ballaststoffreicher Kost fördert dann ein gesünderes und diverseres Mikrobiom.
- Gleichzeitig steigt die Produktion kurzkettiger Fettsäuren, die entzündungshemmend auf die Dickdarmschleimhaut wirken.
Die Forschung zeigt: Die positiven Effekte auf Entzündungswerte, Insulinsensitivität und Blutzuckerkontrolle sind eng mit dieser mikrobiellen Erneuerung verknüpft.
Vom Entlastungstag zum nachhaltigen Effekt
Das klassische Buchinger-Programm ist ein dreiphasiger, oft ärztlich begleiteter Prozess:
- Entlastungtage: Leichte Kost bereitet den Körper vor.
- Fastenphase (5-21 Tage): Nur flüssige Nahrung wie Gemüsebrühe und Säfte, rund 250 kcal täglich.
- Kostaufbau: Das behutsame Wiedereinführen fester Nahrung ist der wichtigste Schritt, um den Darm nicht zu überfordern.
Interessant: Beim Fastenbrechen steigen oft immunmodulatorische Proteine im Blut – ein Zeichen für eine Reaktivierung der Abwehrkräfte. Doch die Bakterienzusammensetzung kann nach etwa drei Monaten in den Ursprungszustand zurückkehren. Was bedeutet das? Die Ernährung nach dem Fasten entscheidet über den dauerhaften Nutzen.
Fasten als Therapie: Mehr als nur Gewichtsverlust
Die neuen Erkenntnisse positionieren das Buchinger-Fasten neu. Es gilt nicht länger nur als Methode zur Gewichtsreduktion, sondern als ernsthafte therapeutische Maßnahme für Darmgesundheit und Prävention.
Die nachgewiesene Verbesserung von Blutdruck, Blutzucker und Blutfettwerten unterstreicht das Potenzial für die Herz-Kreislauf-Gesundheit. Die Zukunft der Forschung könnte in personalisierten Fastenplänen liegen: Basierend auf individuellen Mikrobiom-Analysen ließen sich die gesundheitlichen Vorteile vielleicht noch präziser maximieren.
PS: Veränderungen von Blutzucker, Entzündungsmarkern oder Proteinwerten verunsichern viele Fastende. Der praktische Selbstcheck-Report (25 Seiten) zeigt Schritt für Schritt, wie Sie Laborwerte richtig interpretieren, Fehldiagnosen vermeiden und welche Maßnahmen sinnvoll sind. Ergebnisstatus und Empfehlungen kommen direkt per E‑Mail – ideal für alle, die ihre Fastenwirkung medizinisch einordnen wollen. Jetzt Laborwerte-Report gratis sichern